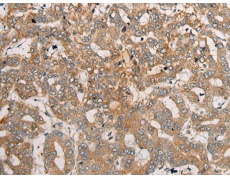
一抗

中文名稱:兔抗CEND1多克隆抗體
英文名稱: Anti-CEND1 rabbit polyclonal antibody
別 名: cell cycle exit and neuronal differentiation 1; BM88
儲(chǔ) 存: 冷凍(-20℃)
宿 主: Rabbit
抗 原: CEND1
反應(yīng)種屬: Human, Mouse, Rat
克隆類型: rabbit polyclonal
技術(shù)規(guī)格
|
Background: |
BM88, also known as CEND1 (cell cycle exit and neuronal differentiation protein 1), is a 149 amino acid protein that belongs to the CEND1 familly. Involved in neuroblastoma cell differentiation, BM88 is a single-pass type IV membrane protein that is neuron specific. It is suggested that BM88 forms a dimer of two identical polypeptides linked by disulfide bridges. BM88 has a central proline-rich region containing four PxxP motifs, which typically bind SRC homology-3 (SH3) domains, as well as a putative C-terminal transmembrane region, and several potential sites for N-glycosylation, myristoylation and phosphorylation. It is also suggested that a novel signaling mechanism exists by which BM88 interferes with calcium release from inositol 1,4,5-trisphosphate-sensitive stores and exerts anti-proliferative and anti-apoptotic functions. BM88 is an important molecular target for HDAC inhibition, and transcription of BM88 is induced by trichostatin-A. |
|
Applications: |
ELISA, IHC |
|
Name of antibody: |
CEND1 |
|
Immunogen: |
Synthetic peptide of human CEND1 |
|
Full name: |
cell cycle exit and neuronal differentiation 1 |
|
Synonyms: |
BM88 |
|
SwissProt: |
Q8N111 |
|
ELISA Recommended dilution: |
5000-10000 |
|
IHC positive control: |
Human liver cancer and human prostate cancer |
|
IHC Recommend dilution: |
25-100 |


 購物車
購物車 幫助
幫助
 021-54845833/15800441009
021-54845833/15800441009